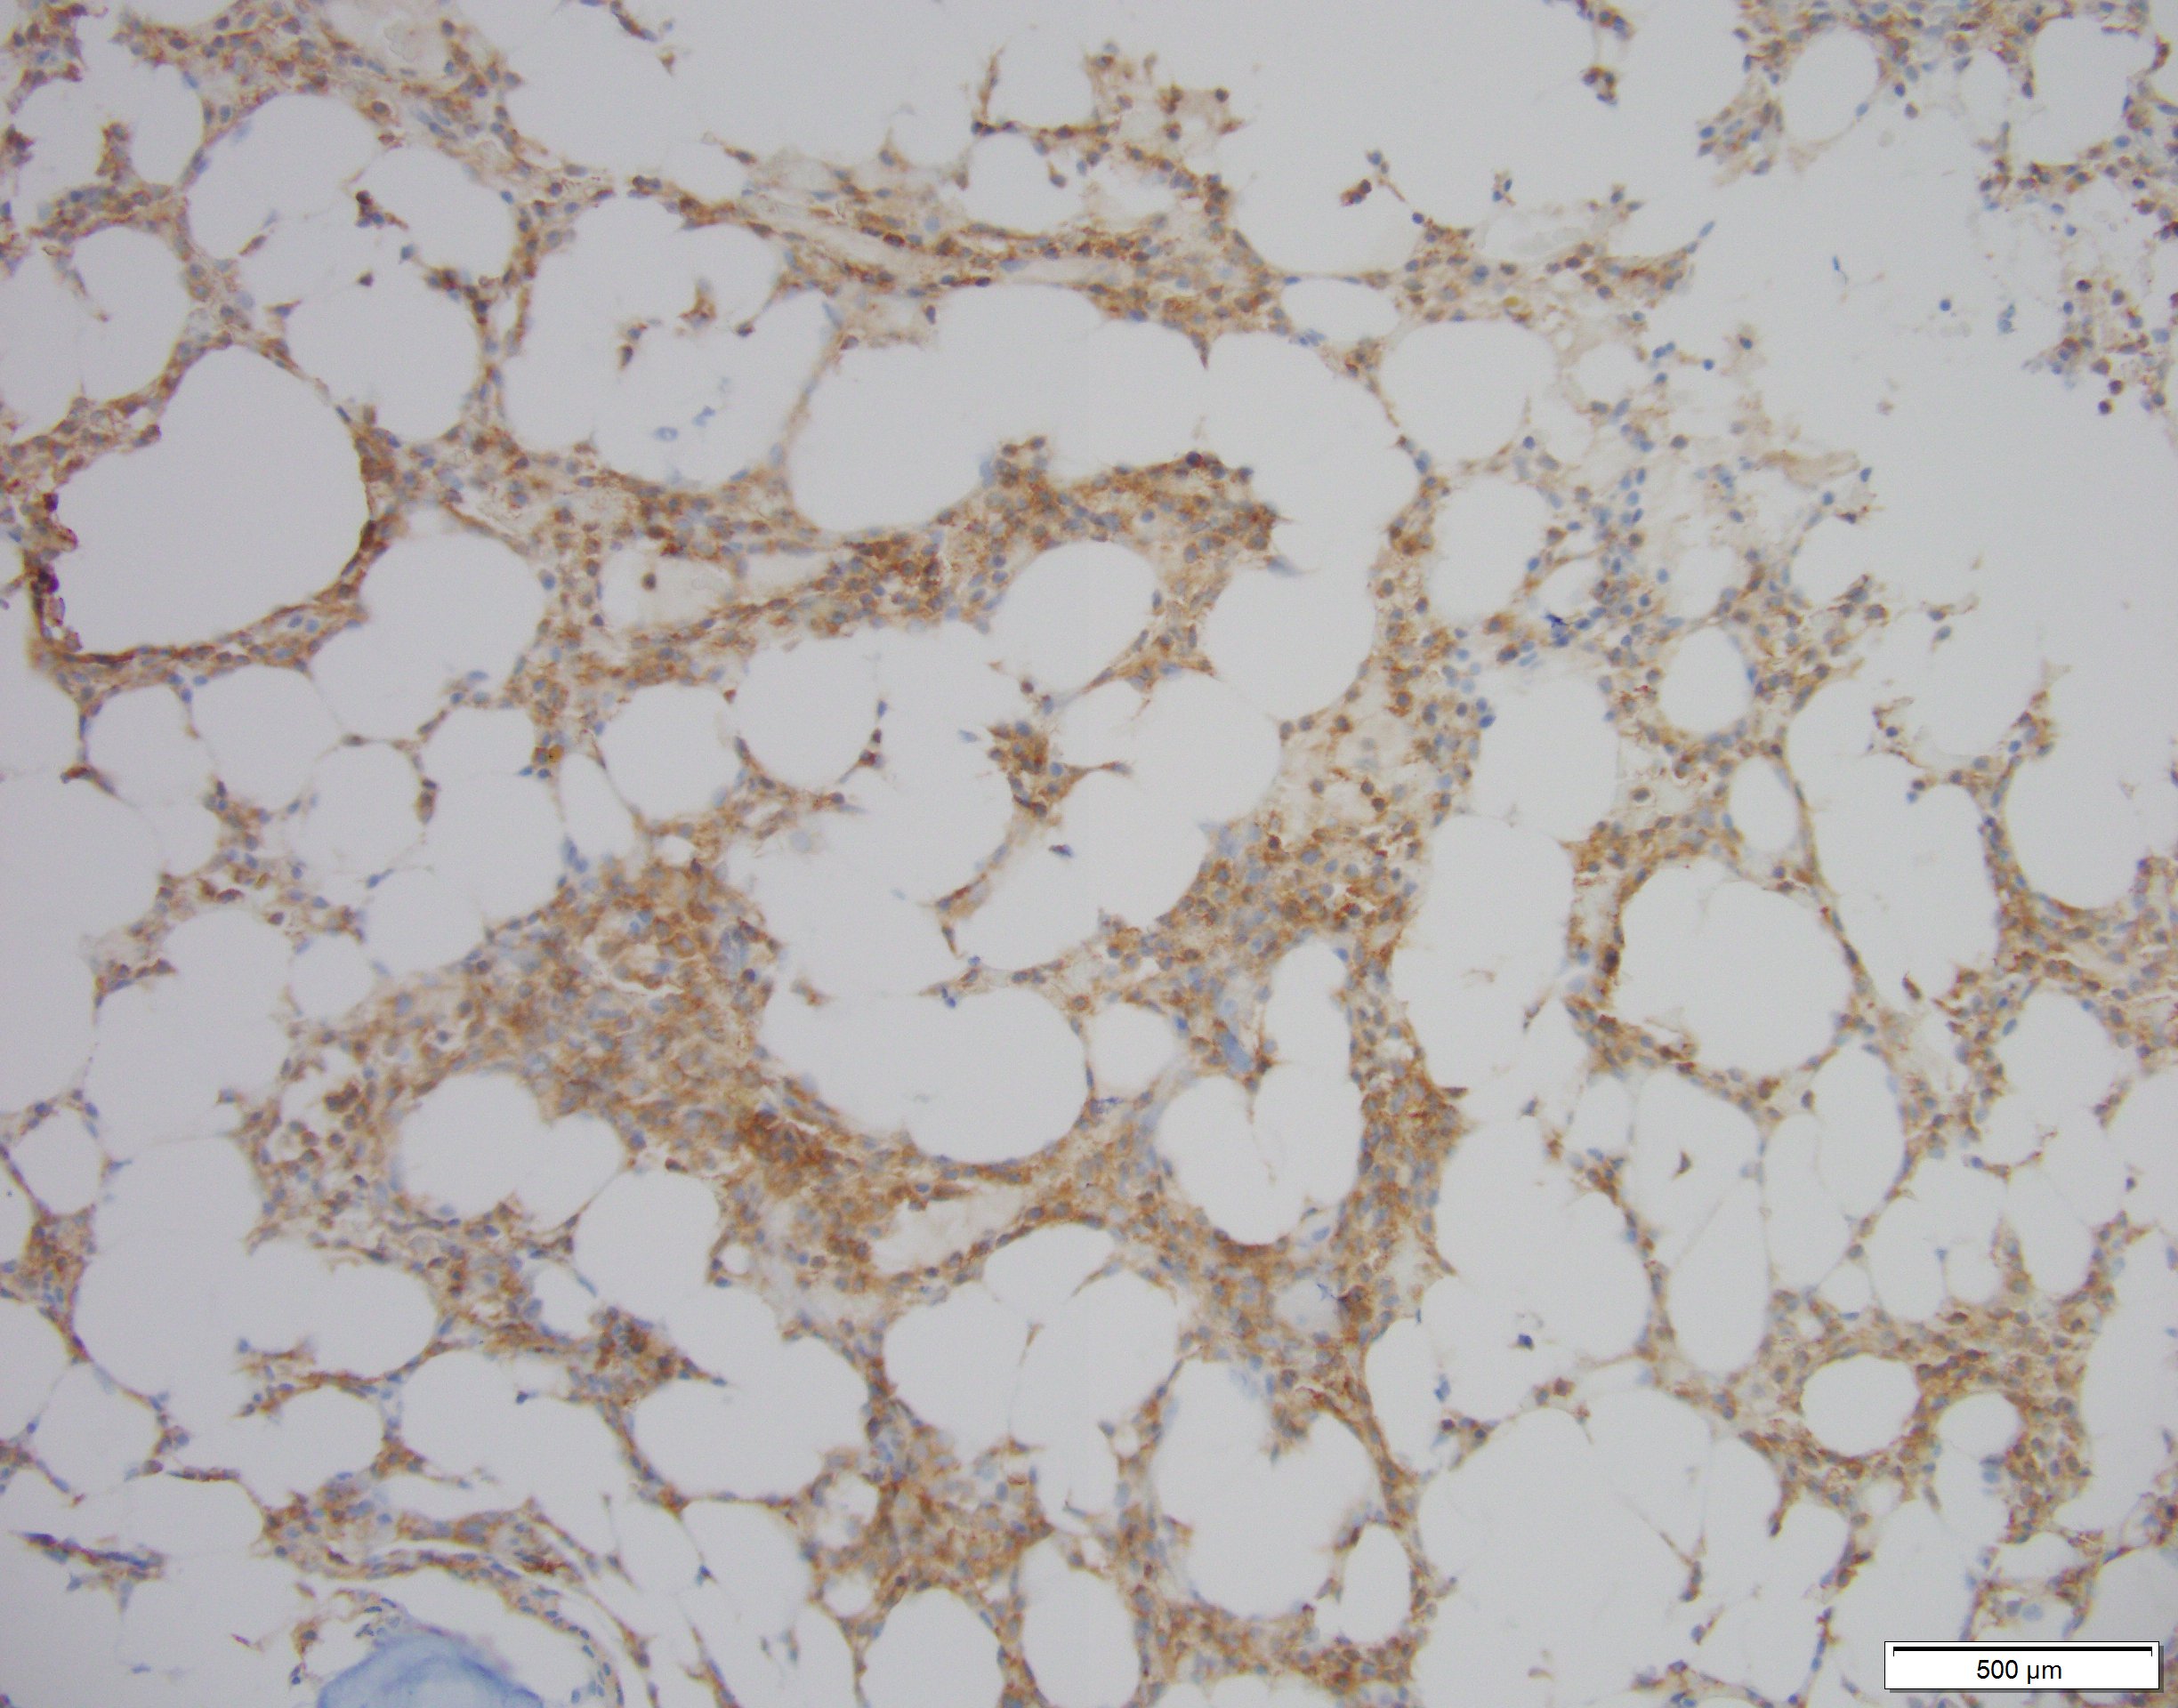
BRAF Answer

Case History
Patient history:
77 year old male with history of prostate cancer, hyperthyroidism, and new progressive pancytopenia. His peripheral blood shows pancytopenia but unremarkable red and white blood cells. His marrow findings are in the pictures.
What entity should be high in your differential?
What is the diagnosis?
- Unremarkable Hypocellular Marrow
- Metastatic Carcinoma
- Hairy Cell
- Myeloid Leukemia


Answer: C: Hairy cell.

Discussion:
Morphologically, this marrow is concerning for hairy cell leukemia. While, the peripheral blood was unremarkable without “hairy cells”, the punched out “fried egg” appearance is concerning for hairy cell leukemia. IHC staining was positive for BRAF, BRAF V600E, CD103, and all supporting this diagnosis. If these stains were negative then other diagnosis including metastatic carcinoma would have to be entertained with an appropriate workup. The key takeaway from this case is consider hairy cell when the morphology on marrow supports it.
Case contributed by: Benjamin Saylor, M.D., PGY6